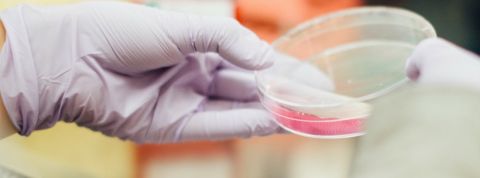
lab Un échantillon en laboratoire

Une start-up américaine propose de séquencer son génome puis de l’authentifier via la blockchain. L’objectif : que chacun puisse ensuite revendre ses données.
Cette technologie permet en effet de certifier une transaction ou authentifier une personne. La blockchain agit donc comme un tiers de confiance à même d’attester du lien véridique entre un individu et son ADN. Pourquoi garantir ce lien ? Pour que ladite personne puisse détenir ces informations et, si elle le désire, les vendre.
De telles données relatives au corps humain coutent en effet cher pour les laboratoires et autres chercheurs. Selon Nebula Genomics, si chaque personne détient son propre ADN séquencé, elle pourra en céder tout ou partie en échange de monnaie sonnante et trébuchante. Finie donc la vente du rein, de sang ou de spermatozoïdes (non-rémunérés en France), place à la marchandisation de ce qui nous constitue.
Tout vendre pour 1 000 dollars
Aussi innovante soit-elle, cette solution soulève de sérieuses interrogations quant au modèle prônant la vente d’un bien inhérent à sa personne. Redonner le pouvoir aux individus en les aidant à se réapproprier leurs informations personnelles va, en soi, dans le bon sens. Toutefois, ce type d’entreprise ouvre un large pan dans le domaine de la marchandisation du corps humain. A terme, il est en effet probable (notamment au vu de la baisse du prix du séquençage de l’ADN) que le prix de vente de ces données diminue fortement. Obligeant les personnes dans le besoin à céder de nouvelles parties de leur être.
Bonjour! En fait je suis très intéressée par cette histoire de vente d'ADN. C'est pourquoi je vous écris dans le souci de savoir le processus afin d'en vendre moi aussi.
bonjour pouvez vous me donner les demarches a suivre pour vendre sont adn merci
Hello, intéressés par ce fait la.. je souhaite savoir comment ET ou on peut vendre son ADN.
Bonjour, intéresser je souhaite savoir comment et où on peut vendre son ADN